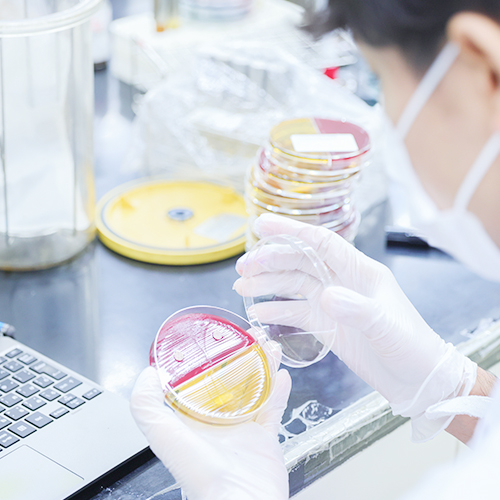

RECRUITMENT GUIDELINES
地域の皆様の
健康を守る
総合保健センターは、
医療機関から委託された検体や血液などの臨床検査や、
健診車での巡回健康診断を行っています。
一人でも多くの方に
健やかな日々を過ごしていただくことを
私たちは願っています。
総合保健センターは、巡回健診と臨床検査の専門機関として、地域の皆さまの健康を、静かに、確かに支えています。
何気ない日常が健やかに続くよう、私たちは正確な検査と誠実な対応を大切にしています。

健康診断
健診車で巡回し、事業所健診、住民健診、学校健診など様々な健康診断を行っています。
臨床検査
医療機関からの臨床検体や健康診断で採取した血液などの、臨床検査を行っています。

腸内細菌検査
食品取扱事業者様や自治体の皆様が、腸内細菌検査(検便)のご依頼をスムーズに行えるようオンラインフォームをご用意しました。
必要事項をご入力いただくだけで、迅速かつ確実に検査準備を進められます。
衛生管理の強化にぜひご活用ください。
私たちは、巡回健診や臨床検査を通じて、人々の健康を守るお手伝いをしています。
医療や健康に関わる仕事を通じて、地域社会に貢献しませんか?
健診や検査を通じて、地域の健康を支える仕事です。医療や福祉に関心のある方、地域に貢献したい方のご応募をお待ちしています。
募集要項
職場の雰囲気や働き方を、数字でわかりやすくご紹介します。実際に働く人たちのデータから、総合保健センターの“リアル”を感じてください。
数字で見る総合保健センター
職員一人ひとりが力を発揮できるよう、働きやすい環境を整えています。職場の様子や雰囲気を、写真とともにご紹介します。
働く環境
健康診断業務や臨床検査業務など多岐にわたる仕事があります。先輩たちの声や一日のスケジュールから、仕事の内容や雰囲気を感じてみてください。
仕事内容
2026年度 年度式および入社式を執り行いました。当日は雨が心配されましたが、なんとか天候も持ちこたえ、桜は少し散り気味ではあったものの、今年は無事に屋外で開催することができました。今年の新入社員は1名。新たな仲間を迎え、気持ちも新たにスタートを切る一日となりました。式の中
日本衛生検査所協会 中部支部検査大会に演者として参加しました。このような機会は中々無い為、とても緊張して本番に臨みました。今回の発表の準備から発表まで非常に良い経験になりました。